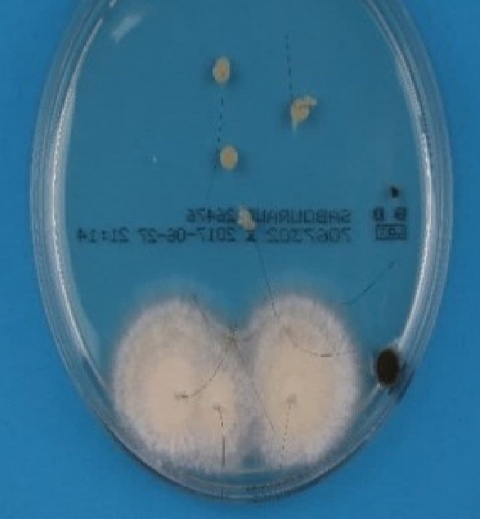

Bundeswehrzentralkrankenhaus Koblenz
Hintergrund
Das Kerion Celsi ist eine seltene hochentzündliche Maximal-variante der Tinea capitis. Charakteristisch ist dabei die Entwicklung schmerzhafter, verkrusteter Läsionen, die mit follikulären Pusteln bedeckt und von erythematösen haarlosen Bereichen umgeben sind, welche sich im Verlauf zu abszessartigen, granulomatösen Formierungen umwandeln. Begleitet wird die Symptomatik von regionalen Lymphknotenschwellungen. Die Abheilung hinterlässt meist eine permanente narbige Alopezie. Hauptauslöser sind in erster Linie zoophile Dermatophyten. Die Diagnose erfolgt mittels kulturellem-, nativem- oder molekularbiologischem (PCR) Erregernachweis.
Fallbeschreibung
Anamnese
Der 20-jährige Patient berichtete bei Vorstellung in der Notaufnahme über eine seit ca. vier Wochen wachsende, rötliche Schwellung am Hinterkopf. Initial lag ein Insektenstich vor, welcher sich im Verlauf zu einer teigigen, nässenden druck-dolenten Schwellung entwickelte. Lediglich eine sporadisch auftretende Abgeschlagenheit wurde im Zusammenhang mit der Symptomatik angegeben, keine relevanten Vorerkrankungen. Als Haustiere wurden vier Ratten angegeben, welche erscheinungsfrei seien.
Hautbefund
Am Hinterkopf linksseitig zeigte sich eine ca. 6 cm durchmessende kissenartig erhabene, purulente, hochrote Hautveränderung mit fest anhaftender gelblicher Pomadenkruste. Die Haare waren zentral leicht ausreißbar. Auf Druck entleerte sich putrides Sekret aus den Follikelöffnungen (Abbildung 1). Restliches Integument und einsehbare Schleimhäute waren unauffällig.
Körperlicher Untersuchungsbefund
Die nuchalen und cervikalen Lymphknoten zeigten sich linksseitig palpabel vergrößert, sonst zeigte sich ein unauffälliger Befund.

Dermatologie und Venerologie, BwZKrhs Koblenz)
Weitere Diagnostik
Von gewonnenen Haarproben wurden mehrere Mycosel- und Sabouraud-Agar-Platten beimpft, ein Nativnachweis war nicht möglich. Ein Wachstum von Trichophyton mentagrophytes konnte auf Sabouraud-Agar-Platten nachgewiesen werden (Abbildung 3). Ebenfalls wurden von den Hausratten Proben entnommen. Bei einer der Ratten konnte ebenfalls Trichophyton mentagrophytes nachgewiesen werden. Die entnommenen Abstriche des putriden Sekretes wiesen reichlich Staphylococcus aureus und nach Anreicherung Serratia marcescens auf.
Verlauf
Bei Verdacht auf eine superinfizierte Trichophytie wurde eine systemische Therapie mit Terbinafin 250 mg (1 x tgl. oral) und Cefuroxim 1,5 g (3 x tgl. i.v.) eingeleitet. Die erweiterte Labordiagnostik auf chronische Infektionen oder immunsuppressive Erkrankungen fiel negativ aus. Lokal erfolgte in mehrfachen Sitzungen eine Abtragung der festanhaftenden Krustenplatte unter Verwendung von antiseptischen Lösungen und Küretten (Vorbehandlung mit einer lidocain-/ prilocainhaltigen Creme). Für die lokale Therapie wurde ein auf Cremebasis basierendes Antimykotikum verwendet, welches im Verlauf durch Ciclopirox-Lösung ersetzt wurde.
Es stellte sich zunächst keine Befundbesserung ein, sodass längliche Inzisionen zur Entleerung der Eiterseen durchgeführt wurden. Zusätzlich wurde 2 – 3 x tgl. eine Kaltplasmabehandlung (2,5 Minuten, Stufe 5, Instrumentensonde PS36) durchgeführt. Es kam zum Sistieren der Sekretion und zu einem langsamen, aber stetigen Rückgang des Kerions.
Diskussion
Dermatologie und Venerologie, BwZKrhs Koblenz)
Die konkrete Diagnosesicherung erwies sich als schwierig, da im nativen Präparat initial kein mykologischer Nachweis gelang und die Auswertung der Kulturen ca. vier Wochen benötigt. Hier wäre der molekularbiologische Nachweis mittels PCR-Diagnostik eine deutliche Zeitersparnis. Bei klinischem Verdacht auf eine bakteriell superinfizierte tiefe Trichophytie wurde eine kombinierte antibiotische und antimykotische Behandlungsstrategie gewählt. Unterstützend erfolgte zudem eine Kaltplasmatherapie als supportive Behandlungsmaßnahme. Durch eine Ionisierung der Umgebungsluft wird hierbei kaltes Plasma erzeugt, welches nachweislich keimreduzierend und wundheilungsfördernd wirkt.
Fazit für die Praxis
- Kerion celsi wird häufig fehldiagnostiziert und erfolglos mit Glukokortikoidexterna, Antibiotika oder chirurgischen Interventionen behandelt.
- Bei Verdacht ist die frühzeitige Einleitung einer systemischen antimykotischen Therapie zur Vermeidung einer permanenten Alopezie obligat.
- Kaltplasmatherapie stellt in der Behandlung infektiöser Wunden eine supportive Therapiemaßnahme dar.
Literatur
- Brissos J, Gouveia C, Neves C, Varandas L: Remember kerion celsi. BMJ Case Reports 2013; bcr2013200594.
- Lloyd G, Friedman G, Jafri S, Schultz G, Fridman A, Harding K:. (2010), Gas Plasma: Medical Uses and Developments in Wound Care. Plasma Processes Polym.2010; 7: 194 – 211.
- Heinlin J, Isbary G, Stolz W et al.: Plasma applications in medicine with a special focus on dermatology. Journal of the European Academy of Dermatology and Venereology 2011; 25: 1 – 11.
Oberstabsarzt Markus Erbel
E-Mail: [email protected]
Datum: 20.12.2018

